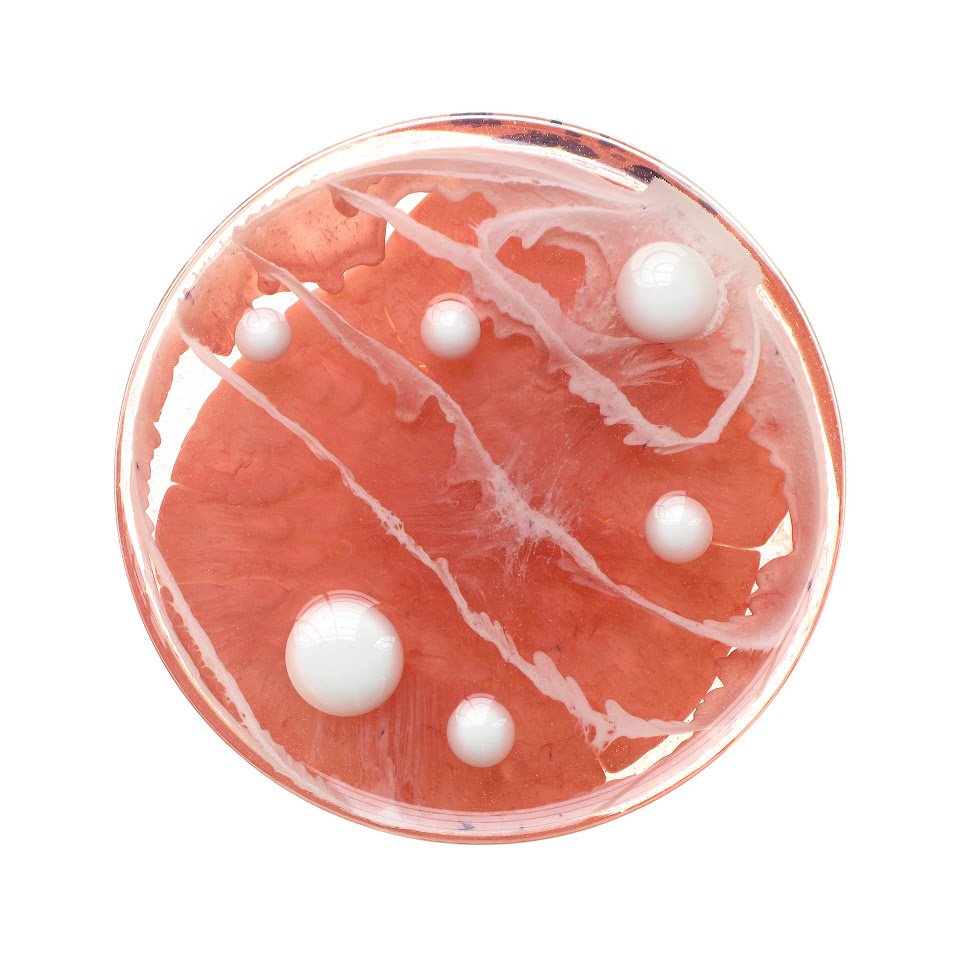

I remember the days back in biology lab when the lab groups in our class would compare petri dishes. Is my agar the right color? Are my colonies of bacteria making pretty clustering? The magnificent world of the petri dish can, in some instances, appear as colorful as art. With this source of inspiration, San Francisco-based artist Klari Reis is pursuing another 365 days of painting petri dishes. Daily Dish 2013, a renewal of the 2009 project, continues to feature brilliant abstract images achieved through layers of reflective epoxy. “Jellyfish with a Brooch” (March 4) is a cerulean with extended tentacles of blue and spotted with a flower of red, while “Funky Onion” (February 4) depicts unfolding sheets upon sheets of vermillion and aqua. With many more dishes to paint, Reis is sure to deliver a collection that dazzles by looks and by quantity.